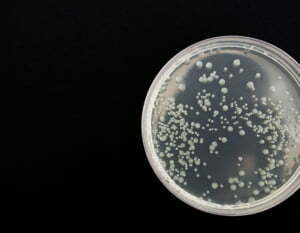
Bakterien in einer Petrischale

29. April: Weltweiter Tag der Immunologie
Der Tag der Immunologie wird seit 2007 jedes Jahr am 29.04. international gefeiert.
Der Tag der Immunologie wird seit 2007 jedes Jahr am 29.04. international gefeiert.
Immunologie wird definiert als die Lehre von den biologischen und biochemischen Grundlagen der körperlichen Abwehr von Krankheitserregern. Dazu zählen u.a. Bakterien, Viren und Pilze.
Inhaltsverzeichnis
Die Bedeutung unseres Immunsystems
Die Immunologie zählt zu den Kernbereichen der Medizin und deren Erkenntnisse tragen wesentlich zum medizinischen Fortschritt bei. Dennoch ist die gesamte Bandbreite ihres Wirkungsbereiches in der Öffentlichkeit weitgehend unbekannt. Ein fehlerhaftes Immunsystem bedeutet eine große Belastung für unseren Körper.
Die Immunologie beschäftigt sich mit dem körpereigenen Abwehrsystem, das in zwei gegenläufige Richtungen entgleisen kann: Entweder in die Richtung der Immundefizienz (körpereigene Abwehrschwäche) oder in die Richtung der Autoimmunität (fehlgeleitete Reaktion des Immunsystems gegen körpereigene Strukturen).
Das Immunsystem spielt bei Krankheiten und klinisch bedeutsamen Vorgängen eine große Rolle. Beispielsweise bei Allergien, bei der Bildung von Tumoren oder bei Autoimmunkrankheiten.
Dieses Video gibt einen Überblick über das Immunsystem:
Die Funktion des Immunsystems nimmt im Alter ab. Die Folgen sind das gehäuft Auftreten von Erkrankungen sowie schlechtes Ansprechen auf Impfungen. Insbesondere Infektionskrankheiten und Tumorerkrankungen können aufgrund des geschwächten Immunsystems oft zu schweren Verläufen führen.
In Versandapotheken Österreichs wie DocMorris findet man mittlerweile zahlreiche rezeptfreie Medikamente, die das Immunsystem stärken sollen. Oft werden diese Medikamente in Form von Kapseln, Tropfen oder Brausetabletten angeboten und enthalten wichtige Vitamine und Mineralstoffe.
Die Geschichte dieses Aktionstages
Der Tag der Immunologie ist eine Initiative der Europäischen Föderation der Immunologischen Gesellschaften und hat 2005 zum ersten Mal stattgefunden. Seit 2007 wird der dieser Tag international gefeiert. Im vergangenen Jahr stand der Tag unter dem Motto „Krebserkrankungen“.
In Österreich hat die immunologische Forschung eine lange Tradition, die bis Ende des 19. Jahrhundert zurückreicht. Bekannte Forscher dieser Periode waren Karl Landsteiner, der Entdecker der Blutgruppen, wofür er 1930 den Nobelpreis für Physiologie und Medizin erhielt, sowie Clemens von Pirquet, der Begründer der Allergielehre.
Rund um den 29. April finden weltweit zahlreiche Veranstaltungen zum Thema Immunsystem statt. Zum einen, um den Menschen dessen Funktion zu erklären und zum anderen, um auf neue Erkenntnisse der Forschung einzugehen. Ziel des Aktionstages ist es, die Öffentlichkeit auf die Wichtigkeit des Immunsystems für die Gesundheit zu sensibilisieren.
Denn noch immer sind viele grundlegende Details über die eigentlichen Reaktionsweisen und deren Relevanz für ein Funktionieren des Immunsystems kaum bekannt. Dieser besondere Tag soll auf die Errungenschaften der immunologischen Forschung aufmerksam machen. Gleichzeitig rücken aber auch die noch ungelösten Herausforderungen ins Blickfeld.
Immunologie im Zusammenhang mit Covid-19
Ein starkes Immunsystem ist wichtig, um Infektionskrankheiten gut überstehen zu können. Menschen mit einem geschwächten Immunsystem, wie z.B. ältere Personen oder Personen mit Vorerkrankungen, zählen zur Risikogruppe, insbesondere bei dem neuartigen Virus Covid-19.
Die MedUni Wien führt derzeit eine Studie zur Analyse der eigenen Körperabwehr nach einer Coronavirus-Infektion durch. Die ForscherInnen am Zentrum für Pathophysiologie, Infektiologie und Immunologie entwickeln dabei einen komplexen Test, der untersucht, ob die Antikörper das Andocken des Virus an die Wirtszellen hemmen können.
Auch eine Untersuchung der zellulären Immunantwort ist geplant. Die Erkenntnisse der Studie sollen eine fundierte Basis für eine Impfstoffentwicklung legen. Personen ab 14 Jahren, die nach einer Covid-19-Erkrankung genesen sind, können daran teilnehmen.
Weiterführende Links:
Studie der Medizinischen Universität Wien



